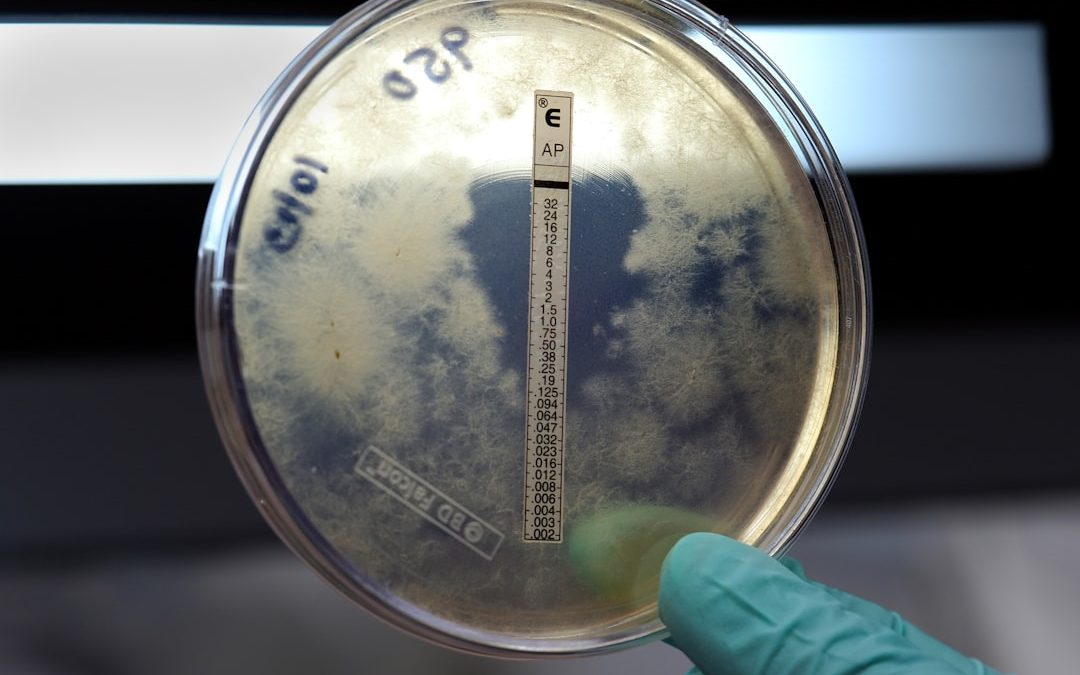
Photo Prescription antifungal

A körömgomba (onychomycosis) egy gyakori gombás fertőzés, amely a körmöket érinti. Leggyakrabban dermatophyták okozzák, de más gombák és élesztők is felelősek lehetnek kialakulásáért. A fertőzés elsősorban a lábujjak körmeit támadja meg, de a kézkörmökön is előfordulhat.
Kialakulását elősegíthetik olyan tényezők, mint a meleg, nedves környezet, sérült köröm, legyengült immunrendszer vagy cukorbetegség. A körömgomba jellemző tünetei közé tartozik a köröm elszíneződése, megvastagodása és töredezettsége. Emellett viszketést és kellemetlen szagot is okozhat.
A fertőzés könnyen terjed közösségi helyeken, például uszodákban vagy zuhanyzókban. Fontos megjegyezni, hogy a körömgomba nem csupán esztétikai probléma. Kezelés nélkül a fertőzés súlyosbodhat és továbbterjedhet, ami egészségügyi kockázatot jelenthet.
Ezért elengedhetetlen a korai felismerés és megfelelő kezelés. A megelőzés érdekében ajánlott a lábak tisztán és szárazon tartása, valamint a közös használatú nedves felületek kerülése.
Hogyan lehet felismerni a körömgombát?
A fertőzés jellegzetes tünetei
A körömgomba felismerése általában nem nehéz, mivel számos jellegzetes tünettel jár. A fertőzött körömlemez általában elszíneződik, sárgásbarna vagy fehéres foltok jelennek meg rajta. A köröm vastagabbá válhat, és repedezetté vagy morzsalékossá válhat.
A fertőzés egyéb tünetei
Emellett a fertőzött terület viszketést és kellemetlen szagot is okozhat. Ha bármelyik ilyen tünetet észleli a körmeinél, fontos minél hamarabb orvoshoz fordulni.
A diagnosztizálás és kezelés
A körömgomba diagnosztizálásához az orvos általában egy mintát vesz a fertőzött körömlemezből, és laboratóriumi vizsgálatnak veti alá. Ez segít azonosítani a fertőzést okozó gombafajtát, ami fontos lehet a megfelelő kezelés kiválasztásához. Fontos azonban megjegyezni, hogy a körömgomba kezelése hosszadalmas folyamat lehet, és fontos az orvossal való együttműködés a sikeres gyógyulás érdekében.
Milyen vényköteles gyógyszerek állnak rendelkezésre a körömgomba kezelésére?
A körömgomba kezelésére számos vényköteles gyógyszer áll rendelkezésre, amelyek közül néhány közvetlenül alkalmazható a fertőzött területre, míg mások szájon át szedhetők. Az aktuális gyógyszerkiválasztás függ a fertőzés súlyosságától, a gombafajtától és más egyéni tényezőktől. Az orvos általában részletes vizsgálat után dönt arról, hogy melyik gyógyszert írja fel.
Az egyik leggyakrabban felírt vényköteles gyógyszer a körömgomba kezelésére az orális antimycoticumok csoportjába tartozó terbinafin. Ez a gyógyszer közvetlenül hat a gombasejtekre, és segít megszüntetni a fertőzést. Emellett léteznek helyi alkalmazású antimycoticumok is, mint például az amorolfin vagy a ciclopirox, amelyeket közvetlenül alkalmaznak a fertőzött területre.
Melyik vényköteles körömgomba elleni gyógyszer a leginkább hatékony?
| Gyógyszer neve | Hatékonyság |
|---|---|
| Lamisil | Nagyon hatékony |
| Sporanox | Nagyon hatékony |
| Diflucan | Közepesen hatékony |
| Nizoral | Közepesen hatékony |
A leginkább hatékony vényköteles körömgomba elleni gyógyszer megválasztása függ a fertőzés súlyosságától és típusától. Az orvos általában részletes vizsgálat után dönt arról, hogy melyik gyógyszert írja fel. Azonban több tanulmány is kimutatta, hogy az orális antimycoticumok csoportjába tartozó terbinafin rendkívül hatékony lehet a körömgomba kezelésében.
A terbinafin közvetlenül hat a gombasejtekre, és segít megszüntetni a fertőzést. Emellett léteznek más helyi alkalmazású antimycoticumok is, mint például az amorolfin vagy a ciclopirox, amelyek szintén hatékonyak lehetnek bizonyos esetekben. Fontos azonban megjegyezni, hogy minden eset más, és az orvos által felírt gyógyszerrel való együttműködés kulcsfontosságú a sikeres gyógyulás érdekében.
Milyen tényezők befolyásolják a gyógyszer kiválasztását?
A gyógyszer kiválasztását számos tényező befolyásolhatja, mint például a fertőzés súlyossága, típusa és az egyéni egészségi állapot. Az orvos általában részletes vizsgálat után dönt arról, hogy melyik gyógyszert írja fel. Fontos figyelembe venni az egyéni egészségi állapotot és az esetleges egyéb betegségeket is, mivel ezek befolyásolhatják a gyógyszer hatékonyságát és mellékhatásait.
Emellett fontos figyelembe venni az esetleges allergiákat vagy intoleranciát bizonyos összetevőkre, mivel ezek befolyásolhatják a gyógyszer választást is. Az orvos által felírt gyógyszerrel való együttműködés kulcsfontosságú a sikeres gyógyulás érdekében, ezért fontos minden kérdést és aggályt megbeszélni az orvossal.
Hogyan kell helyesen alkalmazni a vényköteles körömgomba elleni gyógyszert?
Milyen mellékhatásai lehetnek a vényköteles körömgomba elleni gyógyszereknek?
A vényköteles körömgomba elleni gyógyszereknek számos mellékhatása lehet, amelyek közül néhány igen súlyos is lehet. Az orális antimycoticumoknak például számos lehetséges mellékhatása van, mint például fejfájás, hányinger vagy májfunkciók zavarai. Emellett fontos figyelni az esetleges allergiás reakciókra is, mint például bőrkiütés vagy légúti problémák.
A helyi alkalmazású antimycoticumoknak is lehetnek mellékhatásaik, mint például bőrirritáció vagy égő érzés az alkalmazott területen. Fontos azonban megjegyezni, hogy minden eset más, és az orvos által felírt gyógyszerrel való együttműködés kulcsfontosságú a sikeres gyógyulás érdekében. Ezért fontos minden kérdést és aggályt megbeszélni az orvossal, és azonnal értesíteni őt bármilyen probléma esetén.
A vényköteles körömgomba elleni gyógyszerrel kapcsolatban további információkat találhat a jopatika.hu oldalon. Itt részletesen olvashat a körömgomba kezeléséről, a rendelkezésre álló gyógyszerekről és azok hatékonyságáról. Ha kérdései vannak a vényköteles körömgomba elleni gyógyszerekkel kapcsolatban, érdemes ellátogatnia a fent említett weboldalra.
FAQs
Mi az a vényköteles körömgomba elleni gyógyszer?
A vényköteles körömgomba elleni gyógyszer olyan gyógyszer, amelyet csak orvosi recept alapján lehet beszerezni a gyógyszertárakban. Ezek a gyógyszerek erősebb hatóanyagokat tartalmaznak, és általában súlyosabb esetekben alkalmazzák őket.
Mikor javasolt a vényköteles körömgomba elleni gyógyszer alkalmazása?
A vényköteles körömgomba elleni gyógyszereket általában akkor javasolják, ha a körömgomba már súlyosabb stádiumban van, és a kevésbé erős gyógyszerek nem hoztak eredményt. Ezeket a gyógyszereket általában hosszabb ideig kell szedni, és szigorú orvosi felügyelet mellett alkalmazzák őket.
Milyen mellékhatásai lehetnek a vényköteles körömgomba elleni gyógyszereknek?
A vényköteles körömgomba elleni gyógyszereknek számos mellékhatása lehet, beleértve a gyomorpanaszokat, májproblémákat, bőrreakciókat és egyéb szervi problémákat. Fontos, hogy csak orvosi felügyelet mellett alkalmazzuk ezeket a gyógyszereket, és rendszeresen ellenőrizzük a szervezetünk reakcióit.
Milyen óvintézkedéseket kell betartani a vényköteles körömgomba elleni gyógyszerek szedése során?
A vényköteles körömgomba elleni gyógyszerek szedése során fontos betartani az orvos által adott utasításokat, és rendszeresen ellenőrizni kell a szervezet reakcióit. Fontos, hogy ne szakítsuk meg a kezelést, és ne változtassunk a gyógyszer adagolásán anélkül, hogy erről előzetesen konzultálnánk orvosunkkal.

Trackback/Pingback